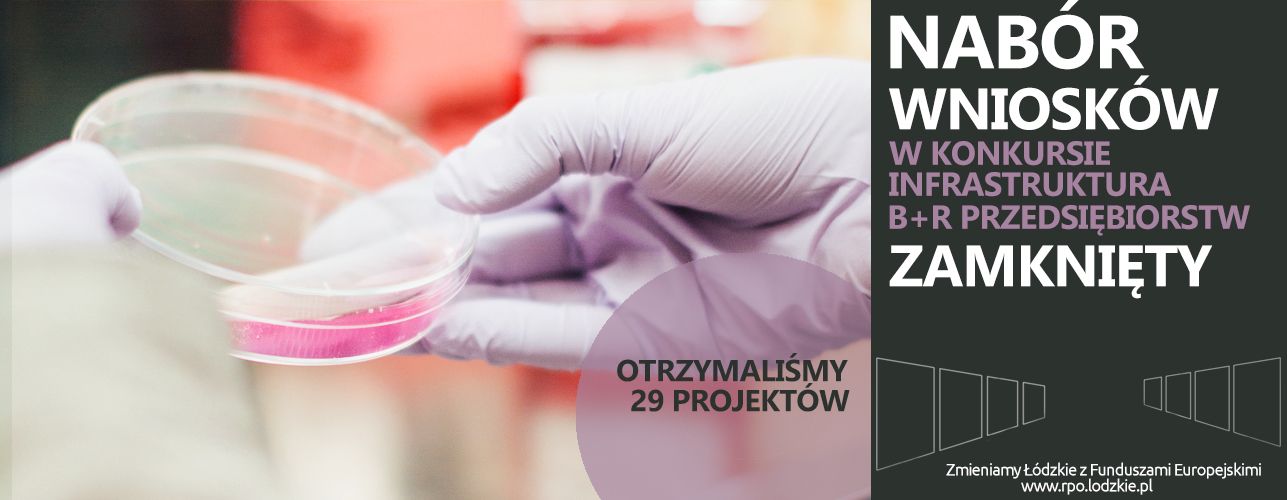

28 kwietnia był ostatnim dniem składania wniosków o dofinansowanie w konkursie na infrastrukturę B+R przedsiębiorstw.
Nabór trwał od 18 do 28 kwietnia i w rezultacie otrzymaliśmy 29 projektów o wartości ogółem w wysokości 90,63 mln zł. Wartość dofinansowania, o które wystąpili wnioskodawcy wynosi 35,3 mln zł.
Powyższe liczby mogą ulec zmianie z uwagi na możliwość wpływu wniosków drogą pocztową.
Więcej informacji tutaj